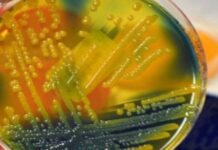
Вчені розробили нанотонкий матеріал для знищення супербактерій

Xiaomi розкрила характеристики Redmi Note 13 + напередодні виходу нових смартфонів
У цьому місяці Xiaomi офіційно представить в Китаї свою нову лінійку смартфонів — Redmi Note 13.
© Gizmochina
Згідно з останніми даними, серія буде результатом співпраці...
У WhatsApp вже почали з’являтися сліди функції для листування з користувачами Telegram і Viber
В останньому бета-оновленні WhatsApp для Android, версії 2.23.19.8, розробники почали впроваджувати підтримку чатів з користувачами інших месенджерів.
Цей крок є частиною дотримання нових європейських законів,...
Ходьба знижує ризик ураження кісткового мозку в коліні — дослідження
Найбільш поширене в світі захворювання суглобів — остеоартрит (ОА) — є основною причиною інвалідності серед дорослих старше 50 років. Результати досліджень вчених з Австралії...
Вчені розробили нанотонкий матеріал для знищення супербактерій
Дослідники розробили нанотехнологію на основі чорного фосфору, яка може вбити більше 99% стійких до ліків бактерій. Цей інноваційний матеріал, який розкладається при контакті з...
Екстракт кульбаби виявився ефективним при лікуванні раку молочної залози
У недавньому дослідженні, опублікованому в Scientific Reports, дослідники оцінили антиметастатичні і антипроліферативні властивості повністю транс-ретиноєвої кислоти (ATRA) і екстракту кульбаби в клітинах раку молочної...
iPhone 15 Pro Max: чем удивит новая модель смартфона
Наконец все почитатели техники Apple могут приобрести желанную новинку. iPhone 15 Pro Max https://www.foxtrot.com.ua/ru/shop/mobilnye_telefony_apple-iphone-15-pro-max.html стал обсуждаемым еще до выхода в продажу. Флагманский смартфон обладает...